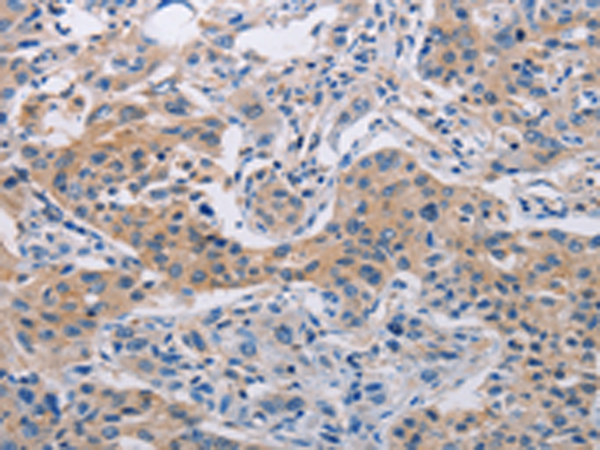

别名:MCH4; ALPS2; FLICE2应用:IHC
反应种属:Human
规格:50μl/100μl
| Description |
|---|
| This gene encodes a protein which is a member of the cysteine-aspartic acid protease (caspase) family. Sequential activation of caspases plays a central role in the execution-phase of cell apoptosis. Caspases exist as inactive proenzymes which undergo proteolytic processing at conserved aspartic residues to produce two subunits, large and small, that dimerize to form the active enzyme. This protein cleaves and activates caspases 3 and 7, and the protein itself is processed by caspase 8. Mutations in this gene are associated with type IIA autoimmune lymphoproliferative syndrome, non-Hodgkin lymphoma and gastric cancer. Alternatively spliced transcript variants encoding different isoforms have been described for this gene. |
| Specification | |
|---|---|
| Aliases | MCH4; ALPS2; FLICE2 |
| Swissprot | Q92851 |
| Host/Isotype | Rabbit IgG |
| Storage | Store at 4°C short term. Aliquot and store at -20°C long term. Avoid freeze/thaw cycles. |
| Species Reactivity | Human |
| Immunogen | Fusion protein of human CASP10 |
| Formulation | pH7.4 PBS, 0.05% NaN3, 40% Glycerol |
| Application | |
|---|---|
| IHC | 1/25-1/100 |
| ELISA | 1/2000-1/5000 |
![]() |
The image is immunohistochemistry of paraffin-embedded Human liver cancer tissue using P06994(CASP10 Antibody) at dilution 1/30. (Original magnification: ×200) |
![]() |
The image is immunohistochemistry of paraffin-embedded Human lung cancer tissue using P06994(CASP10 Antibody) at dilution 1/30. (Original magnification: ×200) |
本公司的所有产品仅用于科学研究或者工业应用等非医疗目的,不可用于人类或动物的临床诊断或治疗,非药用,非食用。
暂无评论
本公司的所有产品仅用于科学研究或者工业应用等非医疗目的,不可用于人类或动物的临床诊断或治疗,非药用,非食用。
中文

发表回复